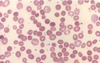
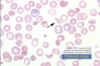

Autoimmune Haemolytic Anemia Flashcards
(20 cards)
what is a test used to detect hemolityc anemias?
why is this test used?
Coombs test or DAT (Direct Antiglobulin Test) test is essential
Patient with autoimmune hemolytic anemias have warm-reactive antibodies of IgG isotype in their red cells
what characterizes autoimmune hemolytic anemias?
1) shortened RBC survival
2) presence of autoantibodies directed against autologus red cells
warm antibody type is for which antibody?
in what diseases can it be used?
IgG
SLE, CLL
Cold agglutinin antibody type is for which antibody?
in what acute diseases can it be used?
in what chronic diseases can it be used?
IgM
Mycoplasma or mononucleosis infection
lymphoplasmacytic lymphoma
cold hemolysin antibody type is for which antibody?
in what diseases can it be used?
IgG
in children after viral infection
Warm antibody type is IgG that has high affinity to what?
what is characterisitc of it?
what can it do with complement?
it can lead to what?
what secondary causes may lead to warm antibody type?
what is the pathogenesis of Warm antibodies type IgG?
human RBC
it is the most common type of warm antibody
it can allow complement to bind
can lead to extravascular hemolysis
SLE, CLL, Penicillin, alpha-methyl dopa
- the patient’s RBCs typically are coated with IgG autoantibodies with or without complement proteins they
- get trapped by macrophages in spleen and Kupffer cells in the liver
- hemolysis is extravascular IgG coated red cells bind to Fc receptors on macrophages which will remove red cell membrane during partial phagocytosis
- red cell become spherocytic
- following loss of membrane these red cells are then broken down in spleen
what is the most common cause of cold agglutinin type?
what other infection can cause it?
what is the pathogenesis?
what symptom may be seen?
Mycoplasma pneumoniae infection
EBV, CMV, Influenza, HIV
- IgM Ab binds to red cells and fixes complement at low temperatures
- when the IgM/C3b-coated RBC circulates to warmer tissues, the IgM dissociates, leaving complement C3b on the original RBC
- remember C3b is an excellent opsonin, which the leads to removal of affected red cells by phagocytes in spleen, liver, and bone marrow
- in infections, this is usually transient and self-limited
Raynaud’s phenomenon may be seen
General Labs for Autoimmune Hemolytic Anemia
Hb
Reticulocytes
Peripheral Blood Smear
Serum Bilirubin
Hemoglobinuria
Haptoglobin
Coombs test
Hb = reduced
Reticulocytes = increased
Peripheral Blood Smear = polychromatophils, nucleated cell
extravascular = spherocytes
intravascular = schistocytes
Serum Bilirubin = raised
Hemoglobinuria = intravascular
Haptoglobin = reduced
Coombs test = positive
What can be said about the RBC?
they look spherocytic
what type of autoimmune hemolytic anemia is this?

cold agglutinin type
What type of Coombs test is the most used?
direct coombs test
what does a Coomb test detect?
what is added to the patient’s RBC?
how do you know the RBC’s are coated with IgG or complement?
presence of antibody or complement coated red cells
compliment or anti-IgG
when they agglutinate
what does an Indirect Coombs test work?
what is mixed with the patients RBC’s?
how do you know if there are antibodies agains the patient’s RBC’s?
detects the presence of antibodies in patient’s serum
IgG and test red cells get mixed with patients serum
agglutination
What are microangiopathic hemolytic anemias?
are these extravacular or intravascular hemolytic anemias?
what can cause this type of hemolytic anemia?
mechanical hemolytic anemias
or
RBC are damaged by contact with endothelium and fibrin
this is a type of intravascular hemolytic anemia
causes:
1) platelet thrombi
2) fibrin thrombi
3) aortic stenosis
what are 2 examples of platelet thrombi causing diseases?
what about fibrin thrombi causing diseases?
Platelet thrombi:
1) hemolytic uremic syndrome
2) thrombotic thrombocytopenic purpura
Fibrin thrombi:
- disseminated intravascular coagulation
- HLLP syndrome (helomytic elevated transaminases, low platelets, associated with preeclampsia)
what are the labs found in microangiopathic hemolytic anemia?
what do you see in the peripheral smear?
normocytic anemia
hemoglobinuria
hemosidenuria
schistocytes present in peripheral blood smear
what is this?
schistocytes
what is the pathogenesis of Rh incopatibility?
What is the major cause of Rh incompatibility?
risk of developing antibodies will increase with what?
- mother has RBC with antibodies (IgG) which go from the placenta into the fetus, destroying its RBC’s.
- Rh (D antigen) negative mother gets immunized by Rh antigen when mother becomes pregnant with Rh positive fetus (immunization either from previous pregnancy/blood transfusion)
D antigen
subsequent pregnancies (if anti-D immunoglobulin prophylaxis is not given)
what are the clinical features of Rh incompatibility?
- hemolytic anemia
- unconjugated hyperbilirubinemia
- risk of developing kernicterus
- unconjugated bilirubin is normally bound to albumin
- liver function is impaired
- albumin synthesis may be reduced
- this increases the risk of kernicterus
what is hemolytic disease of the newborn?
on what blood group infants does this disease happen?
its a ABO incompatibility where hemolysis occurs by non-complement mediated phagocytosis of IgG coated red cells
occurs almost exclusively in infants with blood group A or B who are born to group O mothers (only those who have presence of anti-A & anti-B IgG type antibodies)